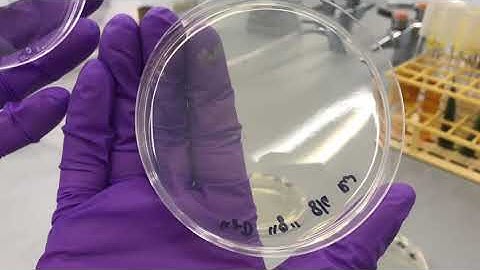
Ubiquity of microorganisms

⬇ DOWNLOAD NOW
Kalau muncul iklan pop-up, tutup lalu klik tombol kembali
Download lagu Micro Lab 2: Ubiquity of Microorganisms, Culturing and Isolating Bacterial Colonies secara gratis hanya untuk keperluan promosi. Dukung artis favorit kamu dengan membeli musik original di iTunes atau platform resmi lainnya.
 Hybrid Micro Lab 2: Ubiquity of Microorganisms, Culturing and Isolating Bacterial Colonies
Hybrid Micro Lab 2: Ubiquity of Microorganisms, Culturing and Isolating Bacterial Colonies
 ONLINE Micro Lab 2: Ubiquity of Microorganisms, Culturing and Isolating Bacterial Colonies
ONLINE Micro Lab 2: Ubiquity of Microorganisms, Culturing and Isolating Bacterial Colonies
 ID Laboratory Videos: Isolating bacterial colonies
ID Laboratory Videos: Isolating bacterial colonies
Ubiquity of microorganisms
Ubiquity of microorganisms
 Streak Plate Technique for The Isolation of Pure Culture_A Complete Procedure (Microbiology)
Streak Plate Technique for The Isolation of Pure Culture_A Complete Procedure (Microbiology)
 Agar plate streaking
Agar plate streaking
 Isolation of Soil Bacteria. #microbiology #bacteria #soil #lablife #microorganisms #science
Isolation of Soil Bacteria. #microbiology #bacteria #soil #lablife #microorganisms #science
 Indole test for E.Coli identification #bacteria #indole #ecoli
Indole test for E.Coli identification #bacteria #indole #ecoli